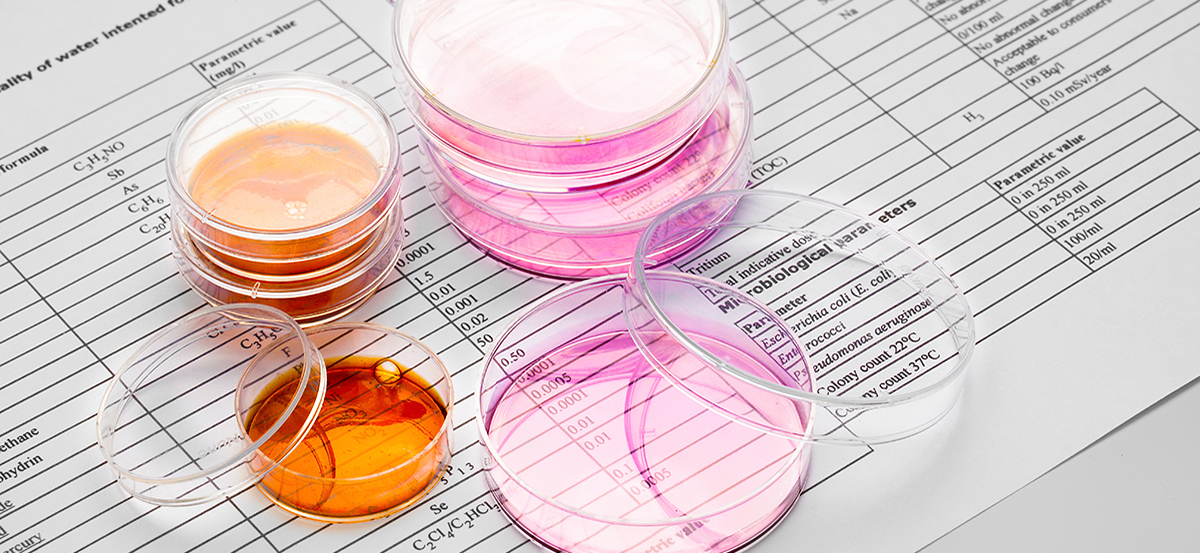

VASSANELLI LAB CERTIFICATIONS
The details that certify a qualified methodology.
Our accreditations and authorisations::
HACCP: self-regulation of the food industries
Laboratory featuring in the Veneto Regional List of laboratories that carry out analysis in the field of self-regulation procedures in food industries; the recognition has validity over the whole national territory.
Fruitmonitoring
All laboratories that wish to analyse samples for participating commercial enterprises and their suppliers of fruit and vegetable products must meet some minimum requirements, defined by fruitmonitoring.com.
The requirements include, amongst others, DIN EN ISO / IEC 17025: 2005 certification in the country where the analysis laboratory is located, as well as regular participation in interlaboratory tests.
The FAPAS, QS or similar interlaboratory tests are recognised.
ACCREDITED LABORATORY ACCREDIA N° 0350 Testing
The term accreditation is the formal recognition of the compliance of a test laboratory with the requirements of the UNI CEI EN ISO / IEC 17025:2018 standard, issued by an accreditation body that operates in compliance with the UNI CEI EN ISO / IEC 17011 standard.
Accreditation is based on verifying the technical competence of the laboratory and performing specific tests or certain types of tests, and on the assessment of the laboratory management system.
WINE SECTOR - MINISTERIAL DECREE 01/12/2022 - G.U.N. 290 OF 13/12/2022 AND SUBSEQUENT
The ministry for Agricultural, Food and Forestry Policies authorises the Vassanelli C. & C. Enocentro Laboratory, over the entire national territory, to release Test Reports (Certificates of analysis) in the wine sector having official status e.g. for export.
DOWNLOAD PDF
OIL SECTOR - MINISTERIAL DECREE 01/12/2022 - G.U.N. 290 OF 13/12/2022 AND SUBSEQUENT
The Ministry for Agricultural, Food and Forest Policies authorises Vassanelli C. & C. Enocentro Laboratory to release official certificates of analysis in the oil sector with official value.
DOWNLOAD PDF
COMPLIANCE WITH THE UNI EN ISO 9001/9002 STANDARD.
Accreditation shows the technical competence of the Enocentro laboratory in carrying out the accredited tests, and the implementation of a quality management system aligned to the principles of ISO 9001: 2000.
ACCREDIA accredited laboratories are deemed suitable for carrying out test activities in support of the certification and inspection activities of accredited bodies.
ISPaVe - Plant Pathology Research Institute.
ISPAVE: Since 2002 Vassanelli C. & C.'s Enocentro Laboratory has been qualified to participate in the "Interregional Program for the qualitative improvement of agricultural production" for the purpose of the "control of the residues of phytosanitary products aimed at the rationalisation of cultivation techniques".
Laboratory recognised by I.S.Pa.Ve. - Plant Pathology Research Institute - for the purpose of the national monitoring of pesticides.